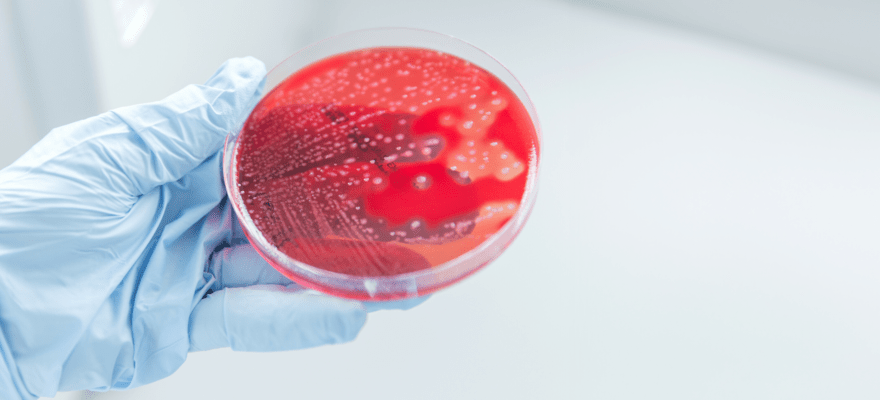

Researcher joins global network to find vaccine for often-deadly Strep A
By Imperial College London - Special to Schulich Medicine & Dentistry Communications
(With files from Cynthia Fazio)
Each year, approximately half a million people, including many children and young people, die around the world because of serious group A streptococcal (Strep A) bacterial infections. While most cases are relatively mild – affecting only the skin or throat – some infections can lead to deadly sepsis or autoimmune damage to the heart. There is currently no available vaccine for Strep A.
Now a researcher from Schulich School of Medicine & Dentistry is joining 27 other investigators from 11 countries in a newly launched network that includes experts in immunology, infectious disease, epidemiology, vaccinology and experimental medicine.
Their goal: Find a vaccine for this often-deadly bacterial infection.
 John McCormick, PhD
John McCormick, PhD
John McCormick, PhD, professor in the Department of Microbiology & Immunology and scientist at Lawson Health Research Institute, will be part of the iSpy Network (immunity to Streptococcus pyogenes), led by Imperial College London alongside the University of California San Diego. The iSpy Network is being supported by the Leducq Foundation.
“This important grant will establish a global collaborative effort of leading clinical researchers and basic scientists all focused on understanding what constitutes a protective immune response to Streptococcus pyogenes,” said McCormick, whose research focus is in the study of bacterial toxins from Streptococcus pyogenes and Staphylococcus aureus. “Streptococcus pyogenes causes diseases such as strep throat, invasive streptococcal disease (the so-called flesh-eating disease) and rheumatic heart disease – a major goal of this grant is to understand the key parts of the bacteria that could be used for developing an effective vaccine to protect against these types of infections.”
A global burden of disease
Group A Streptococcus (or Strep A) commonly causes sore throat and skin infections in younger children and, more rarely, can trigger sepsis and toxic shock when the bacterium enters the bloodstream or tissue. Repeated exposure to Strep A infection can also cause autoimmune damage to the valves of the heart, known as rheumatic heart disease (RHD), which affects an estimated 50 million people worldwide, with most living in low- to middle-income countries (LMICs).
“The RHD patients we see in LMICs generally present with advanced disease and complications such as heart failure,” said Liesl Zuhlke, a paediatric cardiologist at The University of Cape Town and iSpy team member. “Many require cardiac surgery or percutaneous intervention which are often not available, resulting in significant mortality and morbidity and incurring huge out-of-pocket costs to families and communities. We desperately need data on transitions between the various forms of Strep A diseases and how we can intervene to prevent these manifestations.”
Unravelling Strep A immunity
Strep A is highly transmissible and spreads from person to person mostly via the respiratory route from sore throats. Unlike children, adults are mostly immune to Strep A sore throats and skin infections. However, both groups are very susceptible to the invasive form of the infection.
The iSpy-LIFE sub-network will address this through studies in young children, school-age pupils and adults to investigate how ‘good’ immunity to Strep A develops in children after they naturally acquire infections over time. It is hoped this will give a better understanding of what makes people genuinely immune to Strep A, and how a vaccine might emulate and accelerate that immunity in children.
Meanwhile, the iSpy-EXPLORE sub-network will investigate the nature of protective immune cell and antibody responses in experimental animals that receive the most promising Strep A vaccine candidates currently in development. It will also examine how the human immune system reacts when healthy volunteers are experimentally challenged with Strep A infections. Taken together, the work will help scientists understand how we might measure ‘good’ and ‘bad’ immunity to Strep A, paving the way for a future vaccine that protects against strep throat, invasive infections and RHD.
The iSpy Network is being supported by the Leducq Foundation – which is dedicated to improving human health through international efforts to combat cardiovascular disease.








